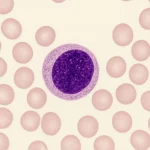

آزمایش لنفوسیت یکی از مهمترین آزمایشهای خونی است که برای ارزیابی سیستم دفاعی بدن انجام میشود. این آزمایش با اندازهگیری تعداد لنفوسیتها در خون، به پزشک کمک میکند تا وضعیت ایمنی بدن را بررسی کند. لنفوسیتها سلولهایی از گلبولهای سفید هستند که با شناسایی و از بین بردن عوامل بیگانه مثل ویروسها، باکتریها و سلولهای سرطانی از بدن محافظت میکنند. با ما همراه باشید تا با این آزمایش آشنا شوید.

آزمایش لنفوسیت چیست؟
آزمایش لنفوسیت آزمایشی است که برای اندازهگیری تعداد سلولهای لنفوسیت در خون انجام میشود. لنفوسیتها یکی از مهمترین اجزای سیستم ایمنی هستند که در دفاع از بدن نقش اساسی دارند. این سلولها در مغز استخوان تولید میشوند و سپس در اندامهایی مثل طحال و غدد لنفاوی رشد میکنند.
در آزمایش لنفوسیت، میزان لنفوسیت در هر میکرولیتر خون اندازهگیری میشود. نتیجه این آزمایش نشان میدهد که بدن تا چه اندازه در مقابل عفونتها و بیماریها مقاومت دارد. انواع لنفوسیتها در بدن عبارتاند از:
- لنفوسیتهای B: تولید آنتیبادی برای مقابله با عوامل بیماریزا.
- لنفوسیتهای T: نابود کردن سلولهای آلوده یا سرطانی.
- سلولهای کشنده طبیعی (NK): از بین بردن سلولهای غیرطبیعی و آلوده.
برای دریافت نوبت و مشاوره از آزمایشگاه جهان کودک بر روی دکمههای زیر کلیک کنید. این مرکز با دستگاه های مدرن و تکنولوژی پیشرفته آماده انجام کلیه تست های بالینی و آسیب شناسی می باشد و آزمایشات توسط تکنسین های با تجربه و با دستگاههای تمام اتوماتیک انجام میشود که در آن خطای انسانی به حداقل میرسد.
آزمایش لنفوسیت چه کاربردی دارد؟
آزمایش لنفوسیت کاربردهای زیادی در تشخیص بیماریها دارد. پزشکان از این تست برای ارزیابی وضعیت ایمنی بدن و بررسی پاسخ بدن به بیماریها و درمانها استفاده میکنند. کاربردهای مهم آزمایش لنفوسیت شامل موارد زیر است:
- تشخیص عفونتهای ویروسی یا باکتریایی: افزایش یا کاهش لنفوسیتها میتواند نشانه وجود عفونت باشد.
- بررسی عملکرد سیستم ایمنی: در افراد مبتلا به بیماریهای خودایمنی یا نقص ایمنی.
- پایش درمانهای خاص: مانند شیمیدرمانی یا داروهای سرکوبکننده ایمنی.
- ارزیابی وضعیت سلامتی کلی بدن: به ویژه در آزمایشهای چکاپ عمومی.
چرا انجام آزمایش لنفوسیت اهمیت دارد؟
آزمایش لنفوسیت اهمیت زیادی دارد چون این سلولها اولین خط دفاعی بدن هستند. هرگونه افزایش یا کاهش در تعداد لنفوسیتها میتواند نشانه بیماری یا ضعف ایمنی باشد.
زمانی که سیستم ایمنی بدن ضعیف شود، احتمال ابتلا به عفونتهای مکرر، تبهای بیدلیل و خستگی بالا میرود. همچنین افزایش بیش از حد لنفوسیتها ممکن است هشداردهنده بیماریهایی مانند لوسمی یا لنفوم باشد. بنابراین این آزمایش به پزشک کمک میکند تا علت دقیق این تغییرات را شناسایی کند.
بیشتر بخوانید: آزمایش لوپوس
آزمایش لنفوسیت چگونه انجام میشود؟
آزمایش لنفوسیت با گرفتن مقدار کمی خون از بازوی فرد انجام میشود. این نمونه خون در آزمایشگاه مورد تجزیه و تحلیل قرار میگیرد. در دستگاه CBC (شمارش کامل سلولهای خونی)، مقدار لنفوسیت بهصورت عددی و درصدی مشخص میشود. مراحل انجام آزمایش به این صورت است که ابتدا محل نمونهگیری با پنبه الکلی تمیزی میشود سپس از طریق ورید بازو با سرنگ نمونه خون گرفته میشود.
نتیجه آزمایش لنفوسیت چه چیزی را نشان میدهد؟
نتیجه آزمایش لنفوسیت نشان میدهد که سیستم ایمنی بدن در چه وضعیتی قرار دارد. این نتیجه به صورت عددی (در هر میکرولیتر خون) و درصدی نسبت به کل گلبولهای سفید گزارش میشود.
| نوع لنفوسیت | محدوده نرمال در بزرگسالان | محدوده نرمال در کودکان |
|---|---|---|
| تعداد مطلق لنفوسیت | ۱۰۰۰ تا ۴۸۰۰ سلول در هر میکرولیتر خون | ۳۰۰۰ تا ۹۵۰۰ سلول |
| درصد لنفوسیت از کل گلبولهای سفید | ۲۰ تا ۴۰ درصد | ۳۰ تا ۶۰ درصد |
اگر مقدار لنفوسیت از حد نرمال کمتر یا بیشتر باشد، پزشک علت آن را بررسی میکند.
چه عواملی میتوانند بر نتیجه آزمایش لنفوسیت تاثیر بگذارند؟
آزمایش لنفوسیت ممکن است تحت تاثیر عوامل مختلفی قرار گیرد که باعث افزایش یا کاهش سطح لنفوسیت در خون میشود.
عوامل افزایش لنفوسیت:
- عفونتهای ویروسی (مثل آنفلوآنزا، هپاتیت، مونونوکلئوز)
- بیماریهای خودایمنی
- استرس طولانیمدت
- بعضی داروها مثل کورتونها
عوامل کاهش لنفوسیت:
- عفونتهای شدید باکتریایی
- درمانهای سرطان مانند شیمیدرمانی
- کمبود مواد مغذی (بهویژه پروتئین و ویتامین B12)
- بیماریهای سیستم ایمنی مانند HIV

چه زمانی پزشک انجام آزمایش لنفوسیت را توصیه میکند؟
آزمایش لنفوسیت زمانی تجویز میشود که فرد علائمی از ضعف ایمنی یا عفونتهای مکرر داشته باشد. پزشک با توجه به نشانهها تصمیم میگیرد که این تست انجام شود. موارد رایج برای انجام آزمایش:
- تبهای طولانی و بدون علت مشخص
- عفونتهای مکرر گلو یا دستگاه تنفسی
- خستگی مزمن و کاهش وزن بیدلیل
- پیگیری بیماران تحت درمان با داروهای سرکوبکننده ایمنی
مقادیر نرمال لنفوسیت در آزمایش خون چقدر است؟
مقادیر نرمال لنفوسیت در افراد مختلف ممکن است کمی متفاوت باشد. در بزرگسالان سالم بین ۱۰۰۰ تا ۴۸۰۰ سلول در هر میکرولیتر خون طبیعی در نظر گرفته میشود.
اگر نتیجه آزمایش بالاتر یا پایینتر از این محدوده باشد، نشاندهنده وجود بیماری یا اختلالی در سیستم ایمنی است که نیاز به بررسی دارد.
بالا یا پایین بودن لنفوسیت در آزمایش خون به چه معناست؟
بالا بودن لنفوسیت (Lymphocytosis) نشانه وجود عفونتهای ویروسی یا برخی سرطانهاست. در مقابل، پایین بودن لنفوسیت (Lymphocytopenia) میتواند به دلیل ضعف سیستم ایمنی، مصرف داروها یا بیماریهای خاص باشد. بالا بودن لنفوسیت در آزمایش خون زمانی رخ میدهد که بدن در حال مبارزه با یک عامل بیماریزا یا تحریک سیستم ایمنی باشد. در بیشتر موارد، افزایش لنفوسیت نشانه وجود عفونتهای ویروسی است.
ویروسهایی مانند سرخک، اوریون، هپاتیت یا مونونوکلئوز عفونی میتوانند باعث افزایش قابل توجه لنفوسیتها شوند. در چنین شرایطی، بدن برای دفاع در برابر ویروسها، تولید این سلولها را افزایش میدهد تا عوامل بیماریزا را از بین ببرد. در برخی موارد، بیماریهای خونی مانند سرطانهای لنفوسیتی یا لوسمی نیز میتوانند باعث بالا رفتن لنفوسیت شوند. در این وضعیت، بدن بهطور غیرطبیعی تعداد زیادی لنفوسیت تولید میکند که ممکن است عملکرد طبیعی خود را از دست بدهند.
همچنین، التهابهای مزمن یا واکنشهای طولانیمدت ایمنی هم از دیگر دلایل افزایش لنفوسیت هستند. این نوع التهابها ممکن است در اثر بیماریهای خودایمنی یا عفونتهای پایدار ایجاد شوند. از سوی دیگر، پایین بودن لنفوسیت در آزمایش خون به معنی ضعف یا اختلال در عملکرد سیستم ایمنی است. یکی از دلایل اصلی کاهش لنفوسیت، عفونتهای شدید باکتریایی است.
در این حالت، بدن برای مقابله با باکتریها از ذخایر لنفوسیت استفاده میکند و ممکن است تعداد آنها کاهش یابد. همچنین، درمانهای دارویی خاص مثل شیمیدرمانی یا مصرف داروهای سرکوبکننده ایمنی میتوانند باعث کاهش سطح لنفوسیت شوند، زیرا این داروها تولید سلولهای ایمنی را مهار میکنند.
در برخی افراد نیز بیماریهای نقص ایمنی مادرزادی یا اکتسابی مانند HIV باعث پایین آمدن لنفوسیت میشود و بدن را در برابر عفونتها آسیبپذیرتر میکند. بهطور کلی، هر دو حالت افزایش یا کاهش لنفوسیت نیاز به بررسی دقیق پزشکی دارند تا علت اصلی مشخص شود و درمان مناسب انجام گیرد.
آیا برای آزمایش لنفوسیت نیاز به آمادگی خاصی وجود دارد؟
آزمایش لنفوسیت به آمادگی خاصی نیاز ندارد. با این حال اگر فرد دارو مصرف میکند یا دچار استرس شدید است، بهتر است پزشک را مطلع کند تا نتیجه دقیقتری به دست آید. در برخی موارد، آزمایش باید صبح و با معده خالی انجام شود و درباره نکات ناشتایی صحیح بهتر است ناشتا بودن قبل از آزمایشها را مطالعه نمایید.
آزمایش لنفوسیت چه تفاوتی با سایر تستهای ایمنی دارد؟
آزمایش لنفوسیت فقط تعداد سلولهای ایمنی خاصی را میسنجد، در حالی که تستهای دیگر مانند ایمونوگلوبولینها یا CD4، عملکرد دقیقتر و جزئیتر سلولهای ایمنی را بررسی میکنند.
این آزمایش پایهایترین تست ایمنی است و در صورت مشاهده ناهنجاری، پزشک ممکن است آزمایشهای تکمیلی برای بررسی عملکرد ایمنی بدن تجویز کند.
آیا مصرف دارو یا استرس میتواند سطح لنفوسیت را تغییر دهد؟
مصرف دارو یا استرس میتواند باعث تغییر سطح لنفوسیت در خون شود. برخی داروها مثل کورتیکواستروئیدها یا داروهای ضدسرطان باعث کاهش لنفوسیت میشوند. از طرف دیگر، استرس و اضطراب زیاد میتواند افزایش موقت سطح لنفوسیت ایجاد کند. این تغییرات موقتی هستند و پس از مدتی به حالت طبیعی بازمیگردند.
چه زمانی لازم است آزمایش لنفوسیت تکرار شود؟
تکرار آزمایش لنفوسیت زمانی انجام میشود که نتیجه آزمایش اول غیرطبیعی باشد یا پزشک بخواهد روند درمان را بررسی کند. مثلا در بیماران مبتلا به HIV یا تحت درمانهای ایمنی، این آزمایش در فواصل زمانی مشخص تکرار میشود تا وضعیت بدن پیگیری شود.

هزینه آزمایش لنفوسیت چقدر است و آیا تحت پوشش بیمه قرار دارد؟
هزینه آزمایش لنفوسیت بسته به نوع آزمایشگاه و محل انجام متفاوت است اما هزینه زیادی ندارد. بیشتر بیمهها این آزمایش را پوشش میدهند، مخصوصا اگر پزشک آن را تجویز کرده باشد. در مراکز درمانی دولتی، هزینه بسیار کمتر است.
بیشتر بخوانید: آزمایش قبل از ازدواج
چه اقداماتی پس از مشاهده نتایج غیرطبیعی لنفوسیت باید انجام شود؟
نتایج غیرطبیعی آزمایش لنفوسیت باید حتما توسط پزشک بررسی شود. اگر مقدار لنفوسیت بالا باشد، ممکن است نیاز به بررسی عفونت یا بیماریهای خونی باشد. در صورت پایین بودن لنفوسیت، پزشک آزمایشهای تکمیلی تجویز میکند تا علت مشخص شود. در بعضی موارد نیز تغییر سبک تغذیه یا مصرف مکملها کمککننده است.
نتیجهگیری
آزمایش لنفوسیت یکی از سادهترین و درعینحال موثرترین روشها برای بررسی سیستم ایمنی بدن است. با انجام این آزمایش میتوان بهموقع بسیاری از مشکلات ایمنی یا عفونتهای پنهان را شناسایی کرد. آگاهی از نتیجه آزمایش و تفسیر صحیح آن کمک میکند تا بدن در برابر بیماریها مقاومتر شود.
سوالات متداول
بله، لنفوسیتها در بخش شمارش گلبولهای سفید در آزمایش CBC گزارش میشوند.
در بعضی موارد بله، چون بدن در برابر عفونتها آسیبپذیرتر میشود و باید علت بررسی شود.
نتیجه در کمتر از ۲۴ ساعت آماده میشود.
بله، کمبود پروتئین، ویتامین B12 و فولات میتواند باعث کاهش لنفوسیت شود.